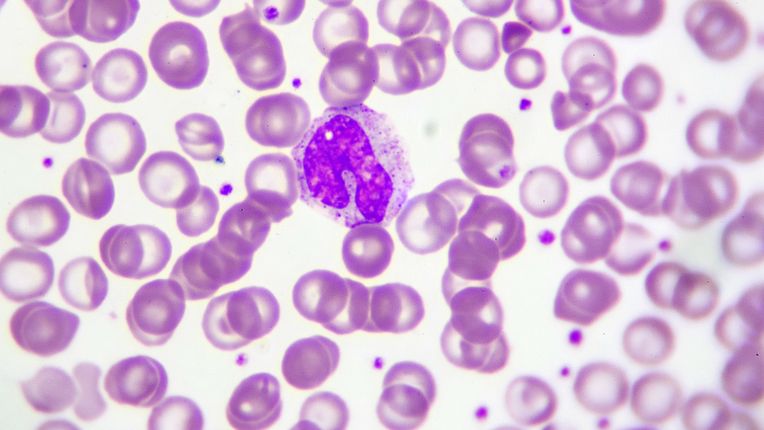
Monocytes : définition, haut, bas, symptômes, prise de sang. Image de monocytes dans un prélèvement au microscope.

Résumé
✅️ Les monocytes sont un type de globules blancs essentiels au système immunitaire.
✅️ Le taux normal de monocytes dans le sang est compris entre 200 et 800 par microlitre de sang.
✅️ Un taux de monocytes élevés, ou monocytose, est synonyme de nombre de situations de santé : infection, cancer, stress, maladie inflammatoire, certains traitements...
✅️ Un taux de monocytes bas, ou monocytopénie peut être la marque d'une infection du sang, d'une chimiotherapie...
✅️ Au vu de vos résultats, trop hauts ou trop bas, votre médecin doit mener des investigations complémentaires pour en diagnostiquer la cause et envisager une réponse possible.
Définition : monocytes
Les monocytes sont un type de globules blancs essentiels au système immunitaire. Les globules blancs sont autrement appelés des leucocytes.
Que sont les monocytes ?
Les monocytes sont les plus grandes cellules circulant dans le sang, avec une taille variant de 15 à 25 micromètres, pouvant atteindre éventuellement jusqu'à 40 micromètres de diamètre.
✍️ À noter : les monocytes représentent environ 1 à 10 % des leucocytes et sont produits dans la moelle osseuse à partir de cellules appelées monoblastes.
Quelle est la fonction des monocytes ?
Les monocytes (qui sont des globules blancs ou leucocytes) jouent un rôle clé dans la lutte contre les infections, l'élimination des tissus endommagés ou morts, la destruction des cellules cancéreuses et la régulation de la réponse immunitaire. Ils aident à lutter contre des agresseurs : agents pathogènes tels que des bactéries, virus et autres micro-organismes nuisibles.
Macrophages
Après avoir été fabriqués dans la moelle, les monocytes circulent dans le sang et peuvent devenir des macrophages (certains parlent de petits macrophages) en infiltrant divers tissus des poumons, du foie, de la rate. A ce stade, passé ce processus, ils phagocytent (ils absorbent et détruisent) les particules étrangères et éliminent les cellules mortes. Les macrophages sont de grosses cellules chargées du nettoyage des grosses cellules ou particules abimées ou étrangères, mais aussi des bactéries.
Les monocytes phagocytent
Les monocytes absorbent et détruisent les agents pathogènes et les débris de cellules.
Immunité
Les monocytes contribuent à une bonne réponse immunitaire.
Inflammation
Les monocytes sécrètent des cytokines pour moduler l’inflammation.
💡 Bon à savoir : En outre, les monocytes, bien que ce ne soit pas leur fonction principale, produisent aussi la prostaglandine, qui joue un rôle dans la coagulation, la reproduction et la protection de l'estomac.
Quel taux de monocytes est inquiétant ?
Taux normal ?
Le nombre de monocytes varie normalement en dessous de 1000/mm³. Le taux normal de monocytes dans le sang est compris entre 200 et 800 par microlilitre de sang (0,20 et 0,80 × 109 par litre). Il existe des variations possibles selon les laboratoires d'analyse (en fonction de leur valeurs de référence).
Qui consulter ?
Contactez votre médecin traitant en cas de monocytes trop haut ou trop bas. Vous pouvez prendre rendez-vous avec un ou une médecin généraliste pour analyser vos resultats et vous orienter si nécessaire.
Cause : que signifie un taux élevé de monocytes ?
Monocytes élevés, monocytose
Une augmentation au-delà de 700 unités par microlitre (0,75 × 109 par litre) des monocytes est connue sous le nom de monocytose. C'est la marque d'une mobilisation du système immunitaire. La monocytose peut être persistante ou transitoire.
Monocytes élevés et infection, cancer, leucémie, allergie, fatigue...
Le système immunitaire peut réagir à:
-
une infection (notamment fongique, en lien avec un champignon)
-
une maladie, comme le paludisme, la candidose,
-
à un cancer,
-
une sarcoïdose,
-
une pathologie hématologique,
-
un type de leucémie : la leucémie myélomonocytaires chronique (LMMC)
-
la maladie de Hodgkin, signalant une stimulation accrue de la moelle osseuse.
-
une allergie,
-
une polyarthrite rhumatoïde...
✍️ À noter : certains traitements comme les corticoïdes et la radiothérapie peuvent faire augmenter le taux de monocytes.
Monocytes élevés et stress
Le nombre de monocytes dans le sang peut rapidement augmenter en réponse à des facteurs tels que le stress (opération, traumatisme), mais revient généralement à la normale peu après.
Monocytes élevés symptômes
Un taux de monocytes peut s'accompagner de ces symptômes (c'est d'ailleurs l'apparition de symptômes qui peut amener le ou la médecin à vous prescrire une prise de sang) :
-
Fatigue : souvent en lien avec une infection ou une maladie inflammatoire...
-
Fièvre : signe d'une activité du système immunitaire en cours contre une possible infection virale, bactérienne, parasitaire...
-
Sueurs nocturnes : symptôme possible d'infection, mais aussi de cancer...
-
Douleurs musculaires et articulaires : en lien avec une possible pathologie inflammatoire...
-
Perte de poids sans raison apparente : signe éventuel de plusieurs maladies graves comme le cancer ou des infections...
-
Gonflement des ganglions : ce symptômes est relié à la présence d'une infection ou d'un cancer...
-
Essoufflement ou palpitation : en lien éventuel avec une maladie cardiaque...
⚠️ Attention : Ces symptômes ne sont donnés qu'à titre indicatif, certains ne sont pas du tout spécifiques. Ils poussent souvent à réaliser une batterie d'examens, comme une prise de sang, pour mesurer les monocytes. Si ces monocytes sont élevés, l'objectif du ou de la médecin sera de vous faire réaliser des examens complémentaires pour poser un diagnostic.
Baisse des monocytes
Bas, monocytopénie
Une diminution en dessous de 200 unités par microlitre (0,20 × 109 par litre) est appelée monocytopénie (la monocytopénie peut être légère ou non) indiquant un manque de monocytes potentiellement dû à une infection du sang ou aux effets secondaires d'une chimiothérapie, voire un trouble de la moelle osseuse.
Conséquences d'une baisse ou d'une hausse des monocytes ?
Un déséquilibre dans le nombre de monocytes, qu'il soit faible ou élevé, ne provoque généralement pas de symptômes en soi, mais il peut être la marque d'une pathologie en cours qui peut être diagnostiquée à cette occasion, d'une réponse inflammatiore etc. Ces variations peuvent être dues à
-
des infections chroniques,
-
des maladies auto-immunes,
-
une inflammation,
-
des troubles de la moelle osseuse,
-
la présence d'un cancer...
💡 Bon à savoir : Le syndrome MonoMAC, une maladie génétique rare, est un exemple spécifique affectant le nombre de monocytes (ils baissent) et augmentant le risque d'infections par divers micro-organismes (bactérie du complexe Mycobacterium avium proche de la tuberculose, voire papillomavirus humain).
Comment mesurer les monocytes ? Prise de sang
Pour cela, il suffit de réaliser une prise de sang. Elle peut être réalisée sans être à jeun. Le médecin analysera votre bilan sanguin. Vous pouvez le retrouver sur les résultats envoyés par le laboratoire d'analyse au paragraphe "numération formule sanguine" (NFS ou hémogramme).
Quel taux de monocytes est associé au cancer ou à la leucémie ?
Un cancer du sang, comme une leucémie, peut entraîner une augmentation des monocytes.
🩸 Tableau comparatif : Monocytes hauts vs monocytes bas
|
Caractéristiques |
Monocytes hauts (Monocytose) |
Monocytes bas (Monocytopénie) |
|---|---|---|
|
Définition |
Augmentation du |
Diminution du nombre |
|
Signification |
Réaction de défense |
Manque de production |
|
Causes possibles |
- Infection (bactérienne, |
- Infection grave |
|
Symptômes associés possibles |
Fatigue, fièvre, sueurs |
Souvent |
|
Examens à réaliser |
Numération formule |
Numération formule |
|
Conduite à tenir |
Consulter un médecin pour identifier la cause. |
Consulter un médecin |
Sources
-
Institut Pasteur Lille, mise à jour 23/02/2025,
Cet article médical a été écrit par un rédacteur expert santé et SEO (EEAT et YMYL), Pierre Luton, et relu et validé par un médecin généraliste au sein d’un établissement ELSAN, groupe leader de l’hospitalisation privée en France. Il a un but uniquement informatif et ne se substitue en aucun cas à l’avis de votre médecin, seul habilité à poser un diagnostic.
Pour établir un diagnostic médical précis et correspondant à votre cas personnel ou en savoir davantage et avoir plus d’informations sur votre pathologie, nous vous rappelons qu’il est indispensable de prendre contact et de consulter un médecin.
Auteur
Article écrit le 10/10/2025, vérifié par Pierre Luton, Journaliste expert, spécialisé santé, social et référenceur SEO EEAT
Prenez tout de suite rendez-vous !
Obtenez un rendez-vous en moins de 5 min avec l'un de nos praticiens en choisissant le créneau horaire qui vous convient le mieux dans un établissement près de chez vous !
Vos questions fréquemment posées sur les monocytes :
Quel est le taux normal de monocytes ?
Le chiffre normal de monocytes est 200 et 800 par microlitre de sang. Attention, les résultats peuvent varier selon les laboratoires d'analyse. Au-dessus, voire en deça, il peut y avoir des anomalies à rechercher et prendre en charge.
Quel est le taux de monocytes inquiétant ?
Un taux de monocytes au-delà de 700 unités par microlitre de sang (0,75 × 109 par litre) des monocytes est connue sous le nom de monocytose. Il n'est pas possible d'envisager des conclusions hâtives ! Il est important de vérifier à quoi cette augmentation correspond car cela peut être un souci de santé passager, résorbable rapidement, voire plus sérieux.
Quelles sont les causes d'une augmentation des monocytes ?
Les monocytes peuvent augmenter à plusieurs occasions :
-
infections,
-
maladies auto-immunes,
-
maladies du sang,
-
certains cancers,
-
sarcoïdose,
-
traitement,
-
stress,
-
effort physique...
Comment faire baisser le taux de monocytes ?
Pour faire baisser le taux de monocytes, mesuré chez une ou un patient, il convient de traiter la ou les causes de la hausse :
-
Antibiotiques en cas d'infection bactérienne (tuberculose), virale (VIH),
-
Prise en charge des affections sous-jacentes : maladies du sans, maladie inflammatoire,
-
Récupération après un stress aigu comme une opération ou un traumatisme,
-
Arrêt de certains traitements (radiothérapie)...
Analyses associées à la Biologie médicale
- Acide folique
- Acide urique
- Acide urique et urée : trois différences
- Albumine
- Cholestérol
- Cholestérol et triglycérides : sept différences
- Créatinine
- Protéine c réactive ou CRP
- CRP : qu’est-ce qu’une inflammation ?
- Taux de CRP pour un cancer, comment savoir s’il faut s’inquiéter ?
- Ferritine
- Gamma GT élevé
- Glycémie
- Hémoglobine
- Hémostase
- Hypoglycémie
- Leucocyturie
- Lipase
- Monocytes
- NFS, numération formule sanguine ou hémogramme
- A partir de quel taux de PSA faut-il s'inquiéter ?
- Polynucléaires basophiles
- Polynucléaires neutrophiles
- Prise de sang
- Triglycérides
- TSH
- Vitesse de sédimentation